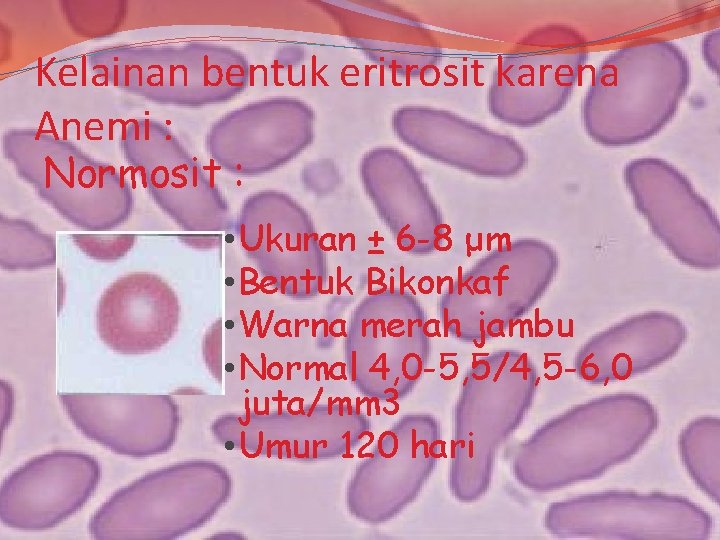
Kelainan bentuk eritrosit karena Anemi : Normosit : • Ukuran ± 6 -8 μm
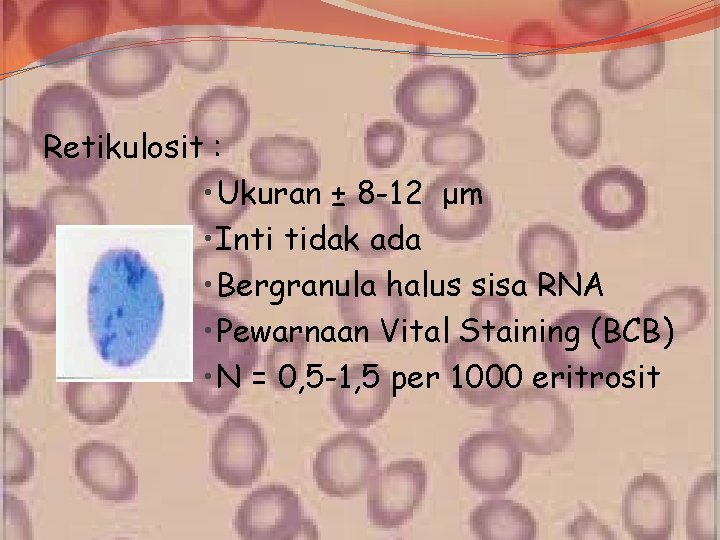
Retikulosit : • Ukuran ± 8 -12 μm • Inti tidak ada • Bergranula
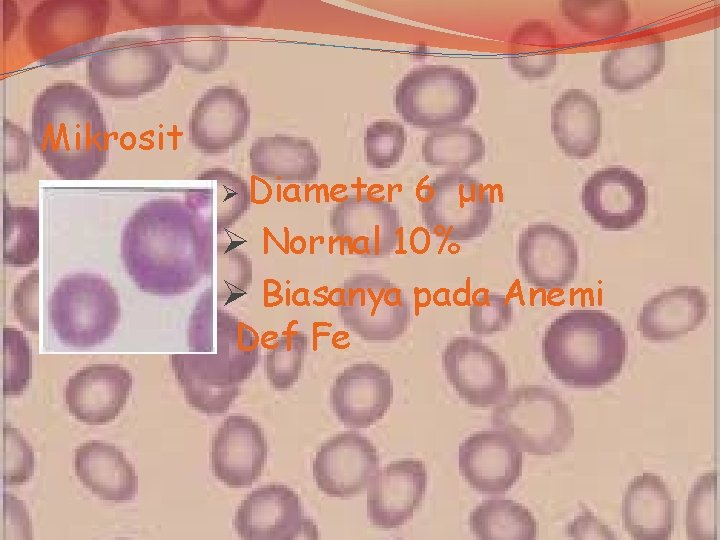
Mikrosit Ø Diameter 6 μm Ø Normal 10% Ø Biasanya pada Anemi Def Fe

KELAINAN BENTUK ERITROSIT OLEH SITI SARAH ERITROSIT Eritrosit

KELAINAN BENTUK ERITROSIT OLEH : SITI SARAH

ERITROSIT �Eritrosit normal memiliki volume sekitar 9 f. L (9 femtoliter) Sekitar sepertiga dari volume diisi oleh hemoglobin, total dari 270 juta molekul hemoglobin, dimana setiap molekul membawa 4 gugus heme. �Orang dewasa memiliki 2– 3 × 1013 eritrosit setiap waktu (wanita memiliki 4 -5 juta eritrosit per mikroliter darah dan pria memiliki 5 -6 juta.
Kelainan bentuk eritrosit karena Anemi : Normosit : • Ukuran ± 6 -8 μm • Bentuk Bikonkaf • Warna merah jambu • Normal 4, 0 -5, 5/4, 5 -6, 0 juta/mm 3 • Umur 120 hari
Retikulosit : • Ukuran ± 8 -12 μm • Inti tidak ada • Bergranula halus sisa RNA • Pewarnaan Vital Staining (BCB) • N = 0, 5 -1, 5 per 1000 eritrosit

Cabot Ring • Eritrosit mengandung cincin Cabot • Penyebab kegagalan eritopoiesis • Terbentuk dari kumparan mitosis • Artefak akibat kerusakan protein

Eliptosit • Eritrosit berbentuk oval (ovalosyt) atau lonjong (pensil cell/sel cerutu) • Osmotic fragility meningkat • Distribusi cholesterol dalam membrane akumulasi • Cholesterol dipinggir
Mikrosit Ø Diameter 6 μm Ø Normal 10% Ø Biasanya pada Anemi Def Fe

Sickle Cell : �Eritrosit yang memanjang dan melengkung dengan 2 katup runcing �Nama lain : Drepanocyt �Eritrosit yang mengalami perubahan bizarre muncul pada keadaan kurang oksigen di udara

- Slides: 9